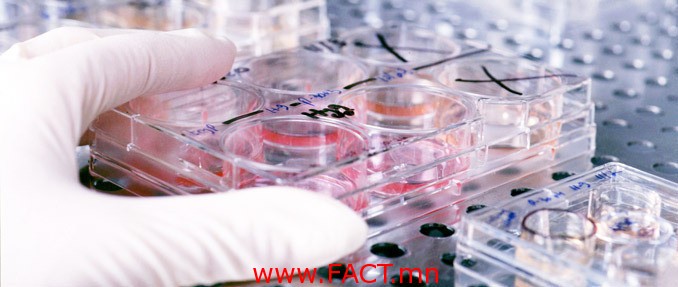
42361b_2103_x678

Хавдрыг эмчлэх шинэ төхөөрөмжтэй болжээ
Хавдар судлалын үндэсний төв хорт хавдрын мэс заслын эмчилгээнд хэрэглэх шинэ тоног төхөөрөмж авчээ.
Сүүлийн жилүүдэд хавдрын чиглэлээр мэргэшсэн эмч, сувилагч нарыг дэлхийн өндөр хөгжилтэй оронд мэргэжил дээшлүүлэх сургалтад хамруулснаар умайн хүзүүний хорт хавдар, хүзүү, толгойн хавдрын мэс заслын эмчилгээг өндөр түвшинд хийдэг болжээ.
Энэ жил умайн хүзүүний хорт хавдрын хэд хэдэн мэс заслыг амжилттай хийсэн байна.
Суддаачдын тооцоолж буйгаар 2025 он гэхэд дэлхийн даяар 19.3 сая хүн хорт хавдраар өвчлөх магаддалтай гэж үзжээ.
Уг өвчний улмаас нас барж байгаа хүмүүсийн олонх нь буурай болон хөгжиж буй орны иргэд байдаг аж Өнгөрсөн жил дэлхий дахинд хорт хавдраар 14.1 сая хүн шинээр өвчилж, 8.2 сая нь нас барсан байна.

URL: